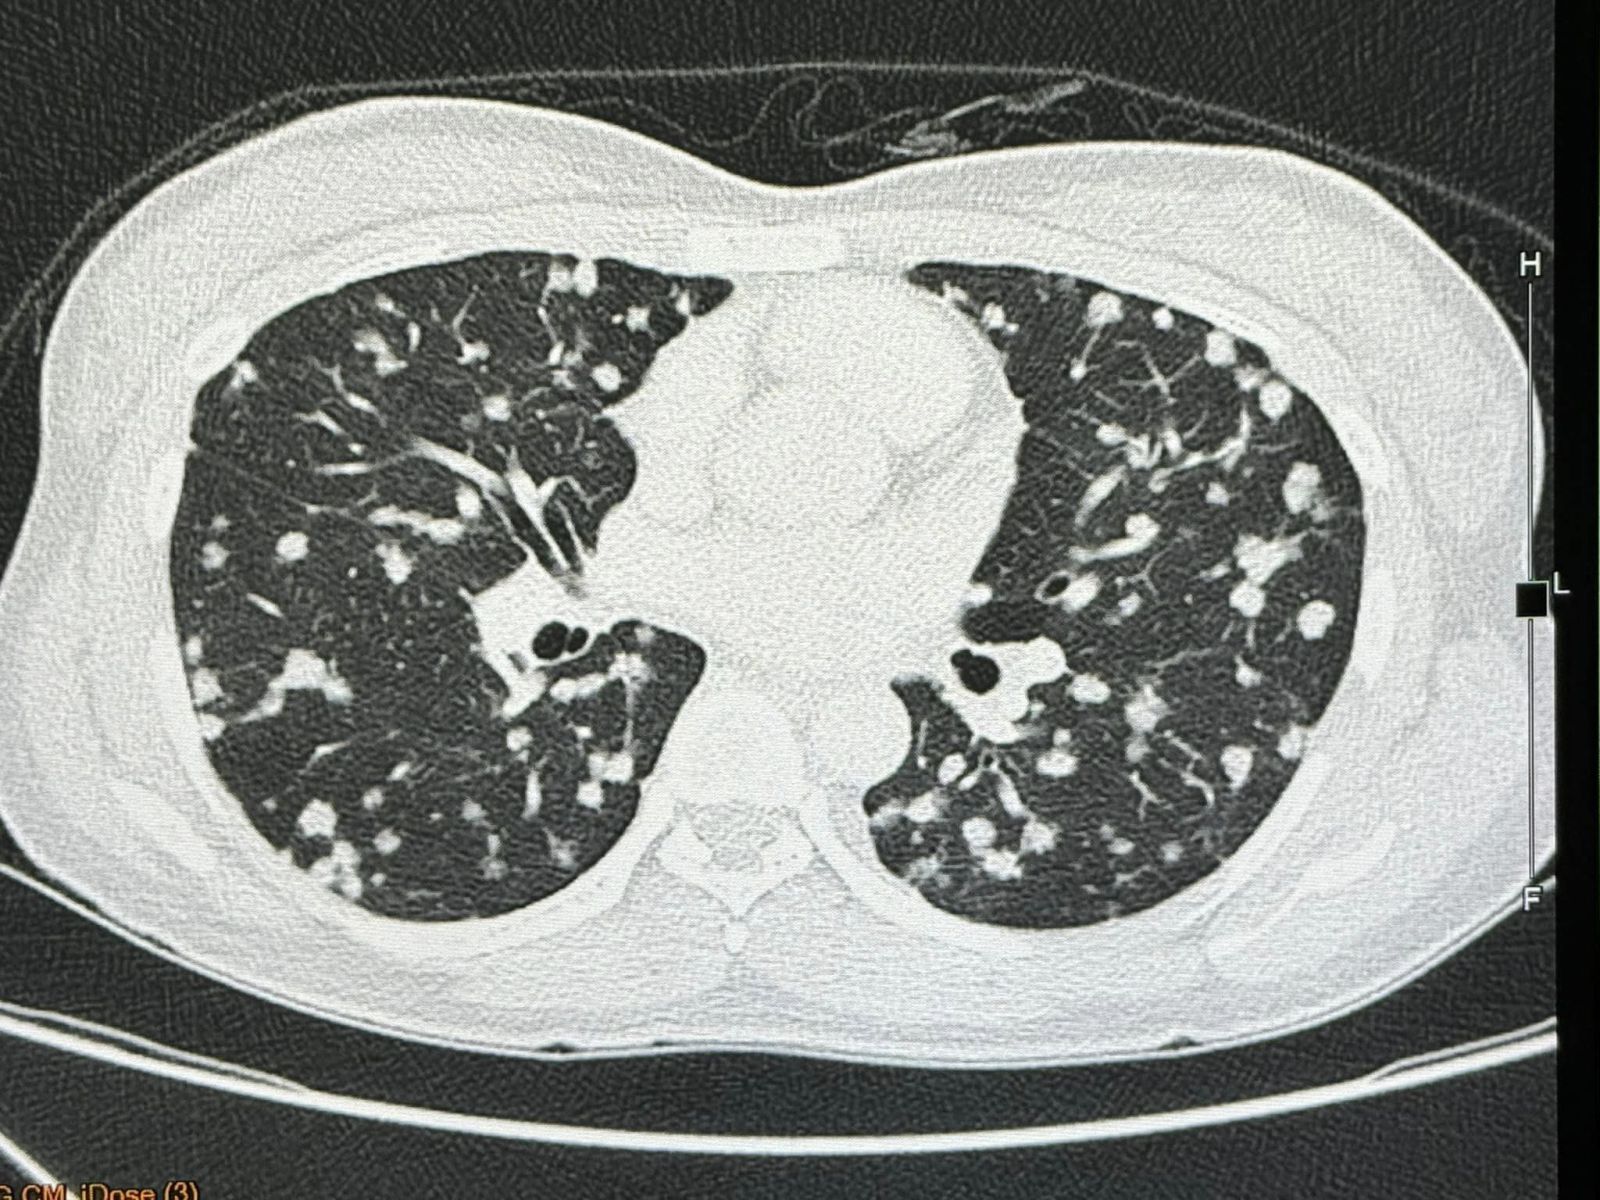

วันที่ 15 กุมภาพันธ์ 2567 เวลา 14:47 น.
15 กุมภาพันธ์ 2567 นพ.มนูญ ลีเชวงวงศ์ แพทย์เฉพาะทางด้านโรคระบบการหายใจ โรงพยาบาลวิชัยยุทธ โพสต์เฟซบุ๊กรูปภาพฟิล์มเอกซเรย์ พร้อมระบุข้อความว่า ผู้ป่วยหญิงอายุ 38 ปี เป็นโรคเลือดจางและเกล็ดเลือดต่ำ 6 ปี ไม่มียาประจำ ไม่กินเหล้าไม่สูบบุหรี่ ไม่มีอาการ ไม่มีไข้ ไม่ไอ ไม่เหนื่อย น้ำหนักไม่ลด ไปตรวจร่างกายประจำปี เอกซเรย์ปอดพบมีจุดเล็กๆ จำนวนมากกระจายในปอดทั้ง 2 ข้าง
ตรวจร่างกายปกติ ฟังปอดปกติ ระดับออกซิเจนในเลือดปกติ เจาะเลือดเม็ดเลือดแดงและเกล็ดเลือดต่ำเล็กน้อย ค่าตับไต ปกติ ค่ามะเร็งทุกตัวปกติ ทำคอมพิวเตอร์ปอดและช่องท้อง พบจุดเล็กๆ ในปอดขนาด 0.8 เซนติเมตรกระจายทั่วปอด และมีก้อนในตับขนาด 3.4 เซนติเมตร ได้ทำการเจาะเนื้อในตับ ย้อมและเพาะเชื้อ ไม่พบเชื้อราและเชื้อวัณโรค ส่งชิ้นเนื้อตรวจพยาธิวิทยา พบ Epithelioid hemangioendothelioma ติดตามผู้ป่วยนับจากวันที่มีเอกซเรย์ปอดผิดปกติ ถึงปัจจุบัน 6 เดือนแล้ว ผู้ป่วยยังไม่มีอาการ
Epithelioid hemangioendothelioma เป็นเนื้องอก จัดเป็นมะเร็งชนิดหายาก เป็นมะเร็งของเซลล์บุผนังด้านในของหลอดเลือด พบน้อยมากๆ 1 คนใน 1 ล้านประชากร
นพ.มนูญ ระบุ อีกว่า "ขณะนี้ผู้ป่วยไม่มีอาการ ติดตามใกล้ชิดต่อไป ถ้าผู้ป่วยเริ่มมีอาการ จะพิจารณาให้ยามุ่งเป้ารักษา"